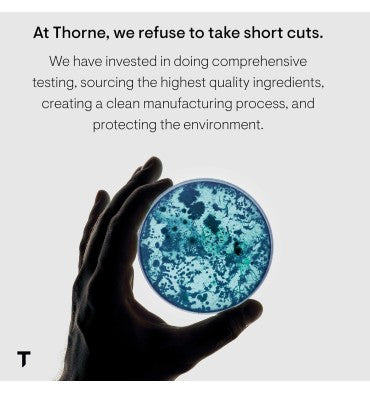

- Sku:
Picolinato de Zinc 15 mg. 60 caps.
$ 460.00
Impuesto incluido.
Los gastos de envío se calculan en la pantalla de pago.
Inventario disponible!
EL MEJOR PRECIO
Compra en línea con el mejor precio en México
ENTREGA RÁPIDA
Enviamos tu pedido al día siguiente hábil
Thorne - Picolinato de Zinc de 15 mg.
Suplemento de Zinc altamente absorbible, promueve bienestar, sistema inmunológico, salud reproductiva, ojos y piel. 60 cápsulas
- Zinc: 15 mg de una forma de zinc de absorción óptima para apoyar el bienestar general, la función inmune, la salud de la piel y el tejido conectivo y la salud ocular*
- Apoyo al sistema inmune: El zinc promueve el funcionamiento óptimo de la respuesta inmune del cuerpo y promueve la activación de un tipo de glóbulo blanco que ayuda a moderar la respuesta inflamatoria del cuerpo durante tiempos de estrés inmunológico*
- Piel y ojos: El zinc promueve una piel y ojos saludables*
- Absorción óptima: Forma de zinc altamente absorbente
- Confianza: Thorne está recomendado por 45,000 profesionales de la salud y más de 100 equipos profesionales y los equipos olímpicos de EE.UU. Thorne es el único fabricante de suplementos que colaborará con Mayo Clinic en la investigación y contenido del bienestar
Have a question?







Picolinato de Zinc 15 mg. 60 caps.
$ 460.00